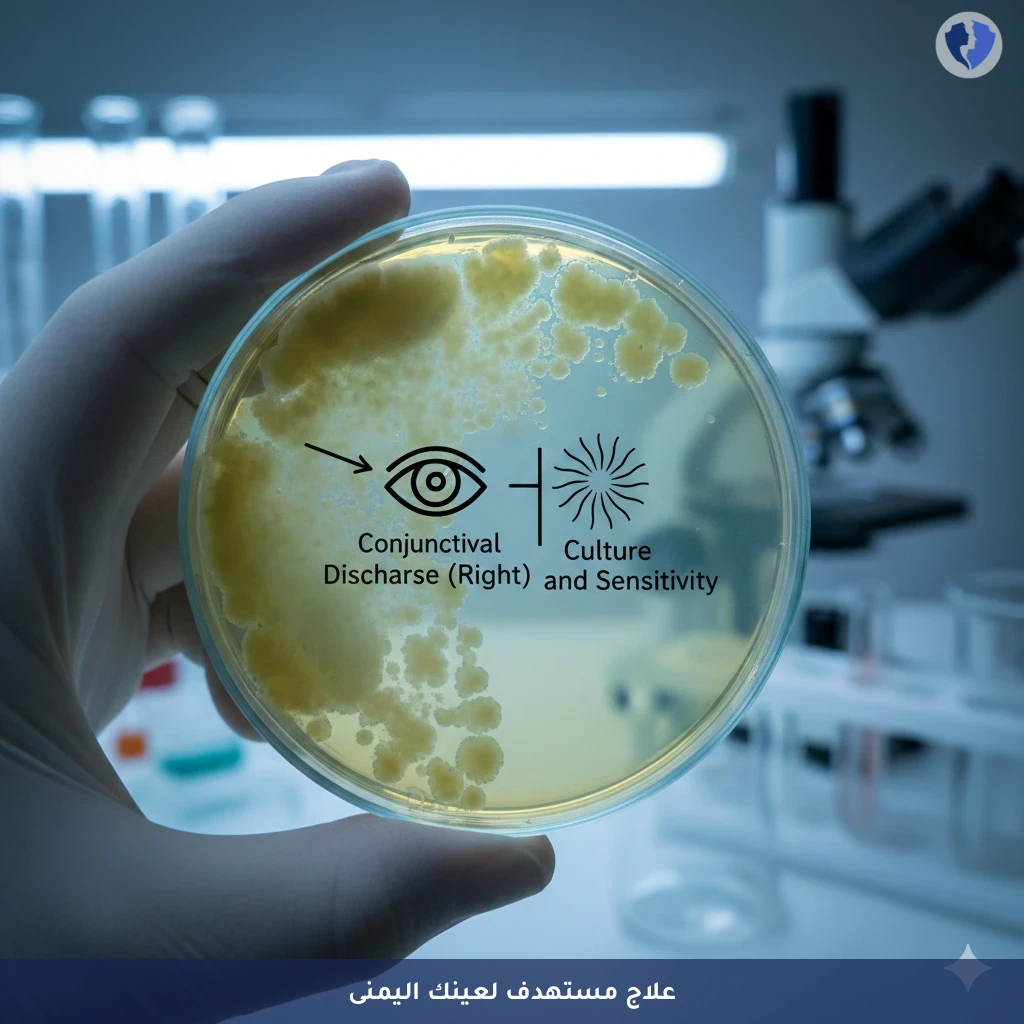
مزرعة إفرازات العين اليمنى - مزرعة إفرازات ملتحمة العين اليمنى مع اختبار الحساسية

تفاصيل الخدمة
مزرعة إفرازات العين اليمنى - مزرعة إفرازات ملتحمة العين اليمنى مع اختبار الحساسية
فحص ميكروبيولوجي يتم إجراؤه على عينة مسحة (سواب) من الإفرازات القيحية أو المخاطية الموجودة في الملتحمة (الغشاء الرقيق المبطن للجفن وداخل العين) للعين اليمنى. يهدف إلى عزل وتحديد البكتيريا أو الفطريات المسببة للعدوى (التهاب الملتحمة الجرثومي أو الفطري)، يليه إجراء اختيار الحساسية (Antibiotic Susceptibility Testing) للمضادات الميكروبية المناسبة لتوجيه العلاج الدقيق والفعال.